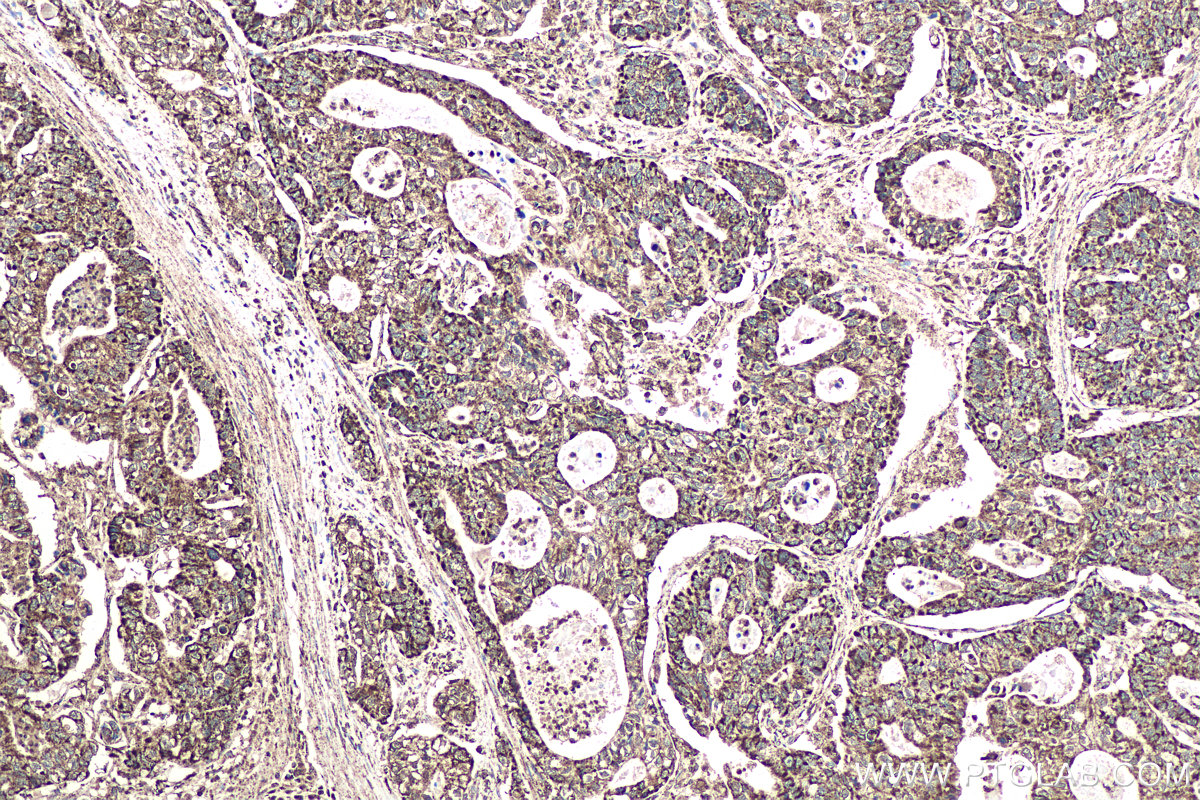

IHCeasy® ATP5D Ready-To-Use IHC Kit
ATP5D Ready-to-use reagent kit for IHC.
Reactivity
Human
Sample Type
FFPE tissue
Cat no : KHC0960
Synonyms
ATP5D, F ATPase delta subunit
Validation Data Gallery
Product Information
KHC0960 is a ready-to-use IHC kit for staining of ATP5D. The kit provides all reagents, from antigen retrieval to cover slip mounting, that require little to no diluting or handling prior to use. Simply apply the reagents to your sample slide according to the protocol and you're steps away from obtaining high-quality IHC data.
| Product name | IHCeasy ATP5D Ready-To-Use IHC Kit |
| Sample type | FFPE tissue |
| Assay type | Immunohistochemistry |
| Primary antibody type | Rabbit Polyclonal |
| Secondary antibody type | Polymer-HRP-Goat anti-Rabbit |
| Reactivity | Human |
Kit components
| Component | Size | Concentration |
|---|---|---|
| Antigen Retrieval Buffer | 100 mL | 50× |
| Washing Buffer | 100 mL ×2 | 20× |
| Blocking Buffer | 5 mL | RTU |
| Primary Antibody | 5 mL | RTU |
| Secondary Antibody | 5 mL | RTU |
| Chromogen Component A | 0.2 mL | RTU |
| Chromogen Component B | 4 mL | RTU |
| Signal Enhancer | 5 mL | RTU |
| Counter Staining Reagent | 5 mL | RTU |
| Mounting Media | 5 mL | RTU |
| Datasheet | 1 Copy | |
| Manual | 1 Copy |
Background Information
The mitochondrial F1Fo-ATP synthase complex uses energy derived from a proton gradient to synthesize ATP. The ATP5D gene encodes the delta subunit of the mitochondrial ATP synthase F1 complex and belongs to the ATPase epsilon chain family.
Properties
| Storage Instructions | All the reagents are stored at 2-8°C. The kit is stable for 6 months from the date of receipt. |
| Synonyms | ATP5D, F ATPase delta subunit |